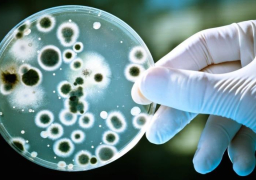
“العلاج بالجراثيم” الثورة المقبلة في الرعاية الصحية

ثقافة
بالصور …. اكتشاف بقايا معبد رومانى بكوم الرصرص بأسوان
نجحت مدرسة الحفائر المصرية المتخصصة في الكشف عن بقايا معبد روماني من الحجر الرملي أثناء عملها بمنطقة كوم الرصرص بمحافظة أسوان، بالتعاون مع منطقة آثار أسوان والنوبة. واوضح الدكتور...
إقرأ المزيد“العلاج بالجراثيم” الثورة المقبلة في الرعاية الصحية
العلاج بالجراثيم.. هذه الكائنات الحية التي تعيش داخل جسدنا دون أن تراها العين المجردة قد تهزّ عالم الأغذية والأدوية! فالـ”الميكروبيوم” أو microbiome، وهو مجموع الكائنات الحية التي تعيش في...
إقرأ المزيدجناح السعودية الأكثر جذبا لجمهور الدورة الـ49 لمعرض القاهرة للكتاب
أكدت هيئة المعارض أن جناح السعودية في الدورة التاسعة والأربعين لمعرض القاهرة الدولي للكتاب التي اختتمت أول أمس السبت؛ حصل على المركز الأول في عدد الزوار. وشغل الجناح السعودي،...
إقرأ المزيدالداخلية: إحباط محاولة أجنبى تهريب 26 قطعة أثرية عبر مطار الأقصر
أفادت وزارة الداخلية، اليوم الأحد، بأن الأجهزة الأمنية بمطار الأقصر الجوى ضبطت أحد الركاب يحمل جنسية دولة أجنبية أثناء إنهاء إجراءات سفره وبحوزته العديد من القطع الأثرية. جاء ذلك...
إقرأ المزيدواقع الحراك الإبداعي في الإمارات يتجلى بمعرض الكتاب
نظمت هيئة الشارقة للكتاب خلال مشاركتها في فعاليات الدورة 49 لمعرض القاهرة الدولي للكتاب، سلسلة من الندوات والجلسات الحوارية الثقافية، كان أبرزها أمسية شعرية بعنوان “شمس القصيد”، وندوة أدبية...
إقرأ المزيدحسناء سورية تنسحب من برنامج ” THE VOICE”بسبب الإرهاب
قررت المتسابقة الفرنسية من أصل سوري منال ابتسام الانسحاب من النسخة الفرنسية للبرنامج العالمي “الصوت” THE VOICE بسبب تغريدات مثيرة للجدل كانت قد نشرتها على موقع التواصل الاجتماعي تويتر....
إقرأ المزيد